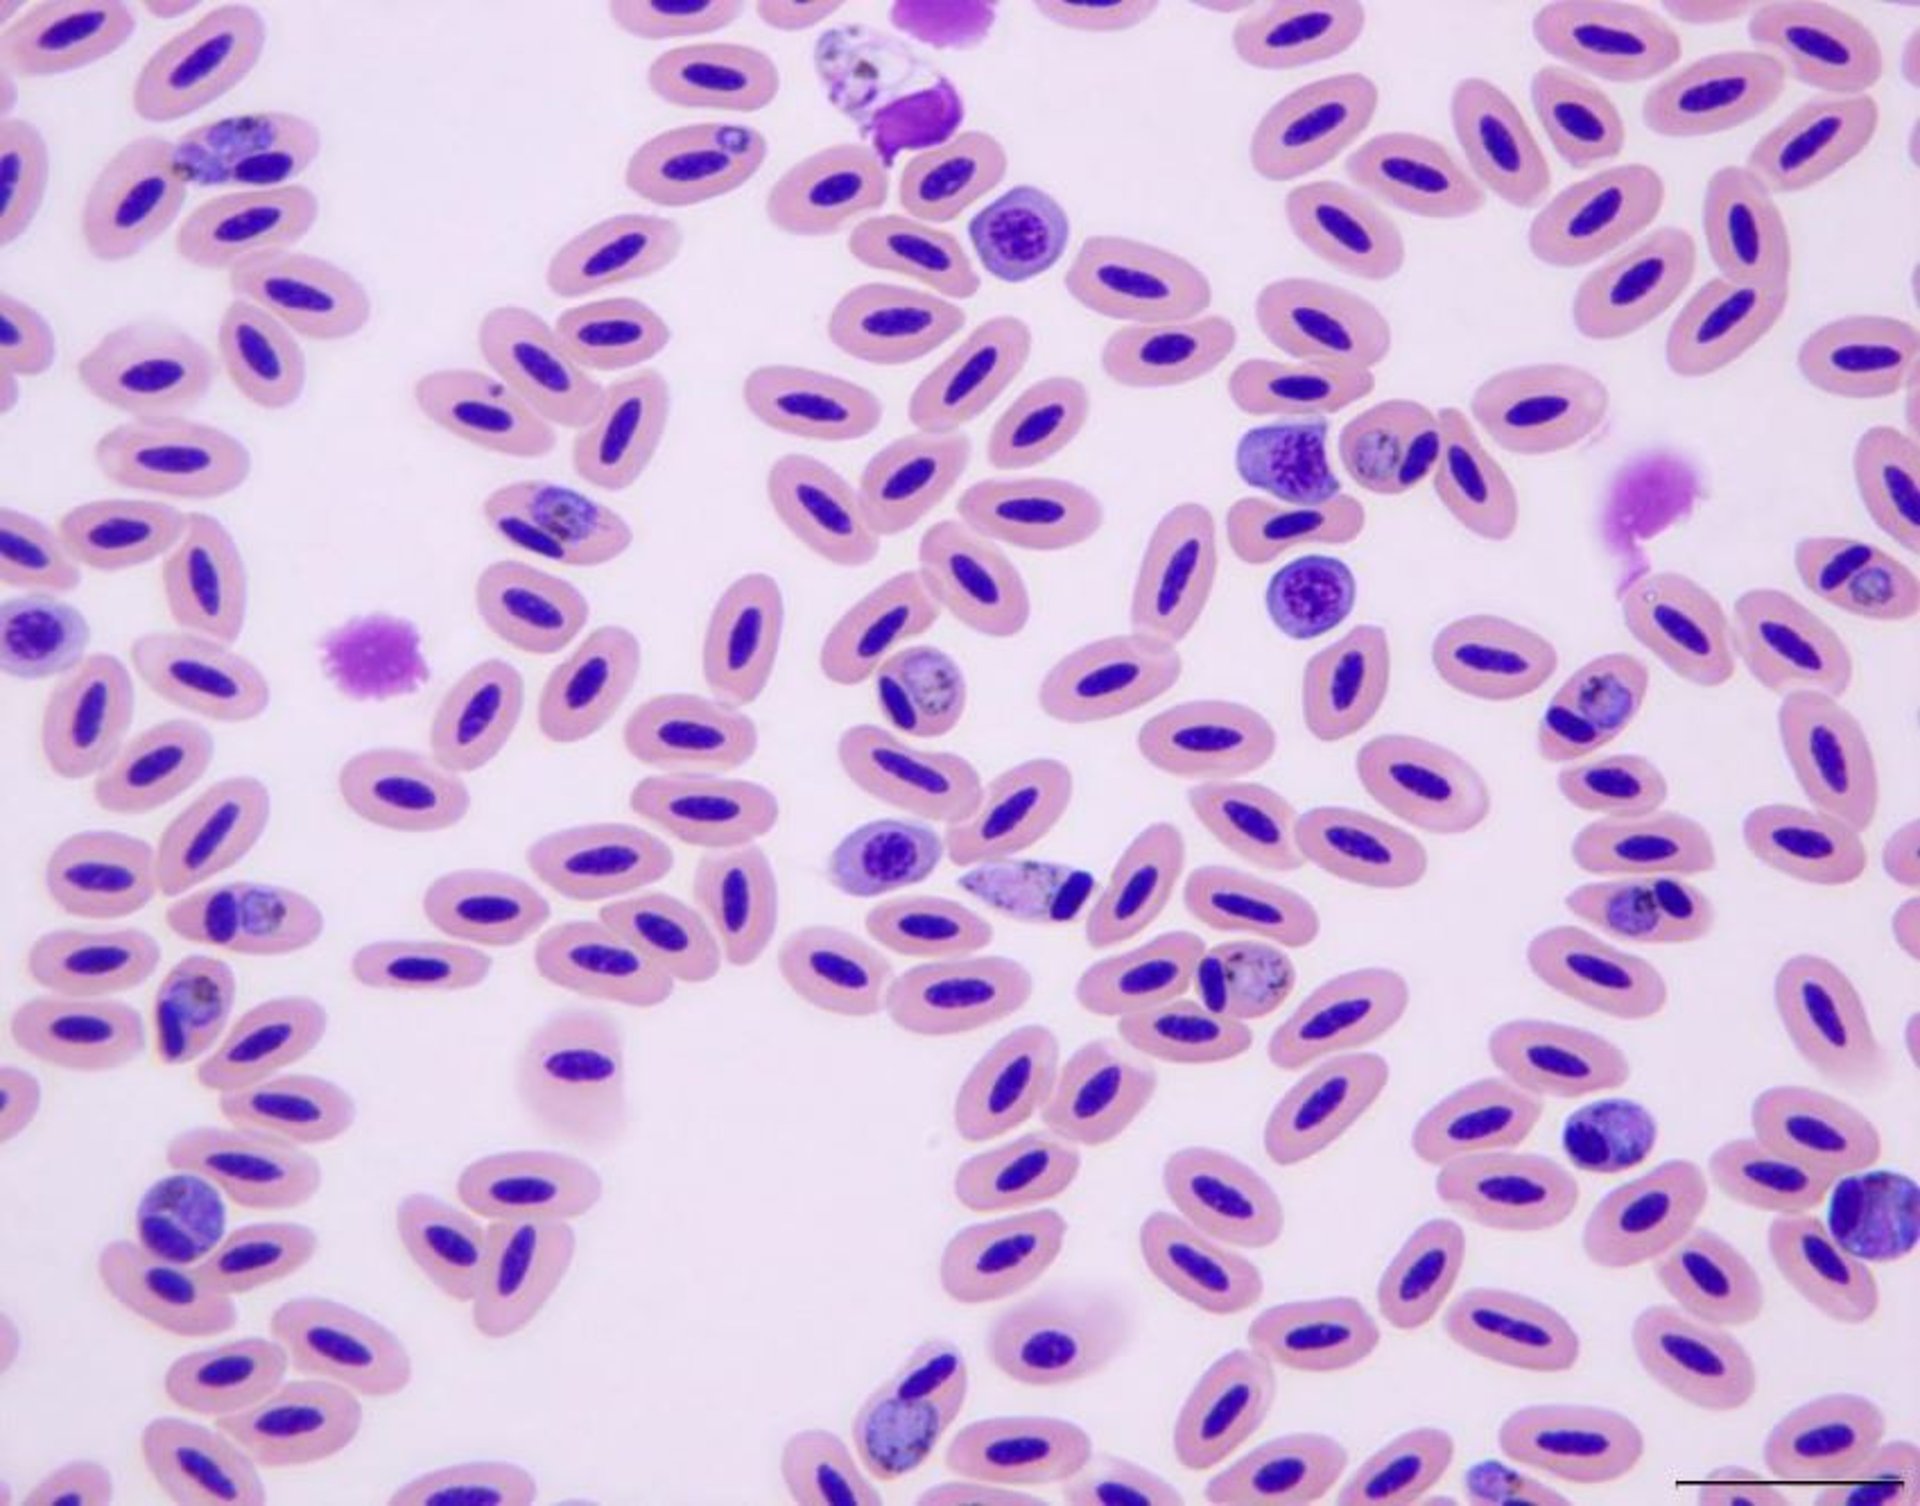
<i >Plasmodium</i> sp, photomicrograph, blood, gyrfalcon

Plasmodium sp, photomicrograph, blood, gyrfalcon
Photomicrograph showing Plasmodium sp in a blood smear from a gyrfalcon (Falco rusticolus). Pigmented gametocytes are present within the cytoplasm of mature and polychromatophilic erythrocytes. Giemsa stain; scale bar = 20 mcm.
Courtesy of Dr. A. J. Van Wettere.
In these topics